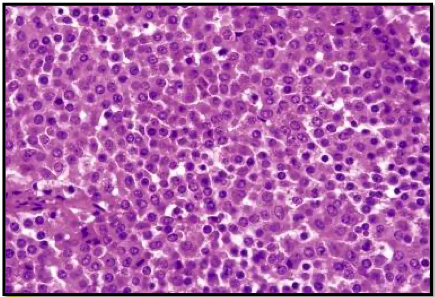

what is the pituitary gland
gland attached to the hypothalamus via infundibulum
location of the pituitary gland
sella turcica of the sphenoid near sensitive structures (optic nerve, internal carotid arteries, cavernous sinuses)
parts of pituitary gland
anterior pituitary: adenohypophysis
posterior pituitary: neurohypophysis
embryologic origins of pituitary gland
Rathke pouch –> anterior pituitary
diencephalon –> posterior pituitary
parts of anterior pituitary
pars distalis, pars tuberalis, pars intermedia
parts of posterior pituitary
infundibulum, pars nervosa
histology of anterior pituitary
- chromophils (secretory cells with basophils and acidophils)
- chromophobes (poorly stained cytoplasm)
histology of posterior pituitary
- infundibulum: nonmyelinated axons
- pars nervosa: axon terminals, pituicytes (supporting glial cells)
identify anterior and posterior pituitary tissue


identify anterior and posterior pituitary tissue


types of anterior pituitary cells
lactotrophs, corticotrophs, thyrotrophs, gonadotrophs, somatotrophs
hormones secreted by anterior pituitary
- GH (somatotroph)
- ACTH (corticotroph)
- TSH (thyrotroph)
- FSH, LH (gonadotroph)
- prolactin (lactotroph/mammotroph)
two hormones that acidophils secrete
GH, prolactin
four hormones that basophils secrete
FSH, LH, ACTH, TSH
hormones secreted by posterior pituitary
- ADH
- oxytocin
identify two of the three categories of anterior pituitary cells


identify the three categories of anterior pituitary cells


histology features of pituitary gland
- pink acidophils
- purple basophils
- chromophobes
- acinar architecture
most common cause of anterior hyperpituitarism
adenomas
identify tissue

normal pituitary
identify tissue
pituitary adenoma
identify tissue

normal pituitary
identify tissue

pituitary adenoma

histology features of pituitary adenoma
- monomorphism of cells
- absence of normal acinar architecture


